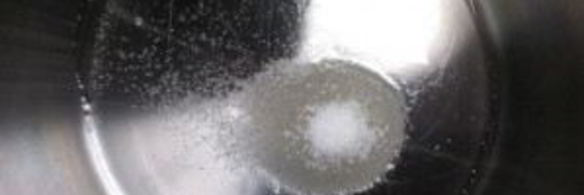
суп из краснокочанной капусты

Ко мне в руки попала красная капуста. Думала я, что с ней сделать. Не хотелось просто рубить ее на салат. Поэтому в поисках интересного я наткнулась на следующий рецепт интересного сурчика. Попробуйте приготовить рецепт щей иза пекинского капуст. Такую вкуснятину Вы еще не пробовали.

Рецепт супа иза краснокочанного капуст
Прочитайте о том, как приготовить суп из краснокочанной капусты. А точнее мы сварим суп-пюре. Он получается кисло-сладким и пикантным. В него будем добавлять вино. Так что, такой суп подойдет для романтического вечера или ужина при свечах. А готовится он не слишком сложно.
Главное не бояться. Все получится. Недавно пробовала . Рекомендую! Может кому и пригодится. Всегда стараюсь приготовить что-нибудь новое.
Капусту нашинкуйте. Лук почистите и мелко нарежьте. Имбирь очистите и натрите на терке.
Растительное масло доведите до кипения с сахаром в сотейнике.
Обжарьте в масле лук до румяного цвета. Затем добавьте капусту. Готовьте овощи, помешивая, в течение 7 минут. Далее влейте вино и выпарите его.

Отдельно подогрейте бульон. Влейте его в капусту. Добавьте имбирь, соль, корицу и перец. Доведите суп до кипения. Варите его в течение 30 минут на слабом огне.

Измельчите суп блендером. Подавайте его с сухой зеленью и сыром. Приятного аппетита!

Комментарии к рецепту
Буду готовить, спасибо за отличный рецепт
Спасибо, все достаточно подробно по шагам расписано!
Спасибо за рецепт, гости были в восторге, очень вкусно.
Супер задумка - буду заглядывать!
Прикольный рецепт
Очень и очень вкусно!
Кстати, спасибо за фото, так гораздо легче готовить супчик.
Предлагаю попробовать щи из пекинской капусты. Мне очень нравится.
Спасибо за рецепт)
Я так долго искала его!
У-у-у-у-у вкусняшка…;)
Приготовила мужу.
Вкус просто потрясающий.
Огромное спасибо от нас обоих.
Это самое вкусное из всего, что я ела в последнее время!!!
А главное, что сделала сама!
Никогда бы не решилась на суп, если бы не доверяла рецептам Цыбулька на все 100%.
Большое СПАСИБО!!!
Все получили огромное удовольствие от супчика.
Раньше делала по-другому, а теперь только так!
Отлично, супчик — супер, понравилось всем!
Я тоже делала.
Оч. вкусно получилось!!!
Спасибо!!!
Рецепты с фото — супер.
После них уже рецепты без фото даже не читаю…
Обленилась.
Хочется видеть, к чему приду.
Цыбулька, спасибо огромное за такой замечательный и легкий рецепт супа!!!
Вчера вычитала, а сегодня уже сделала!
Я молодец!
Спасибо!
Очень вкусно.
За рецепт спасибоооо огромное!!!
Так и хочется приготовить!
Текут слюни прям на клавиатуру..))))))))))))))
спасибки
Давно искала этот рецепт…
Почему-то всё не попадался.
Обязательно приготовлю!
спасибо большое!
Сегодня у сына день рождения, готовим 6 блюд с этого сайта)))))
Получается очень красиво)))